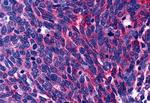
LPAR3 Antibody in Immunohistochemistry (Paraffin) (IHC (P))

Search
Invitrogen
LPAR3 Polyclonal Antibody
{{$productOrderCtrl.translations['antibody.pdp.commerceCard.promotion.promotions']}}
{{$productOrderCtrl.translations['antibody.pdp.commerceCard.promotion.viewpromo']}}
{{$productOrderCtrl.translations['antibody.pdp.commerceCard.promotion.promocode']}}: {{promo.promoCode}} {{promo.promoTitle}} {{promo.promoDescription}}. {{$productOrderCtrl.translations['antibody.pdp.commerceCard.promotion.learnmore']}}
产品信息
PA5-33496
种属反应
宿主/亚型
分类
类型
抗原
偶联物
形式
浓度
规格
纯化类型
保存液
内含物
保存条件
运输条件
RRID
靶标信息
EDG7 is a member of the G protein-coupled receptor family, as well as the EDG family of proteins. This protein functions as a cellular receptor for lysophosphatidic acid and mediates lysophosphatidic acid-evoked calcium mobilization. This receptor couples predominantly to G(q/11) alpha proteins.EDG7 has been reported in human prostate, as well as rodent brain, kidney, lung, placenta, prostate, and testis. ESTs have been isolated from a normal prostate library, as well as cancer libraries of the head/neck, ovary, and thyroid.
仅用于科研。不用于诊断过程。未经明确授权不得转售。
篇参考文献 (0)
生物信息学
蛋白别名: calcium-mobilizing lysophosphatidic acid receptor LP-A3; EDG7; endothelial cell differentiation gene 7; endothelial differentiation, lysophosphatidic acid G-protein-coupled receptor 7; endothelial differentiation, lysophosphatidic acid G-protein-coupled receptor, 7; LPA receptor 3; LPA receptor EDG7; LPA-3; LPA3 Receptor; Lysophosphatidic acid receptor 3; Lysophosphatidic acid receptor Edg-7; putative G protein-coupled receptor snGPCR32; rhodopsin family G protein-coupled receptor; snGPCR32
基因别名: Edg-7; EDG7; GPCR; HOFNH30; LP-A3; LPA3; LPAR3; RP4-678I3
UniProt ID: (Human) Q9UBY5, (Mouse) Q9EQ31, (Rat) Q8K5E0
Entrez Gene ID: (Human) 23566, (Dog) 490187, (Bovine) 532829, (Horse) 100052775, (Mouse) 65086, (Rat) 66025, (Chinese hamster) 100759265